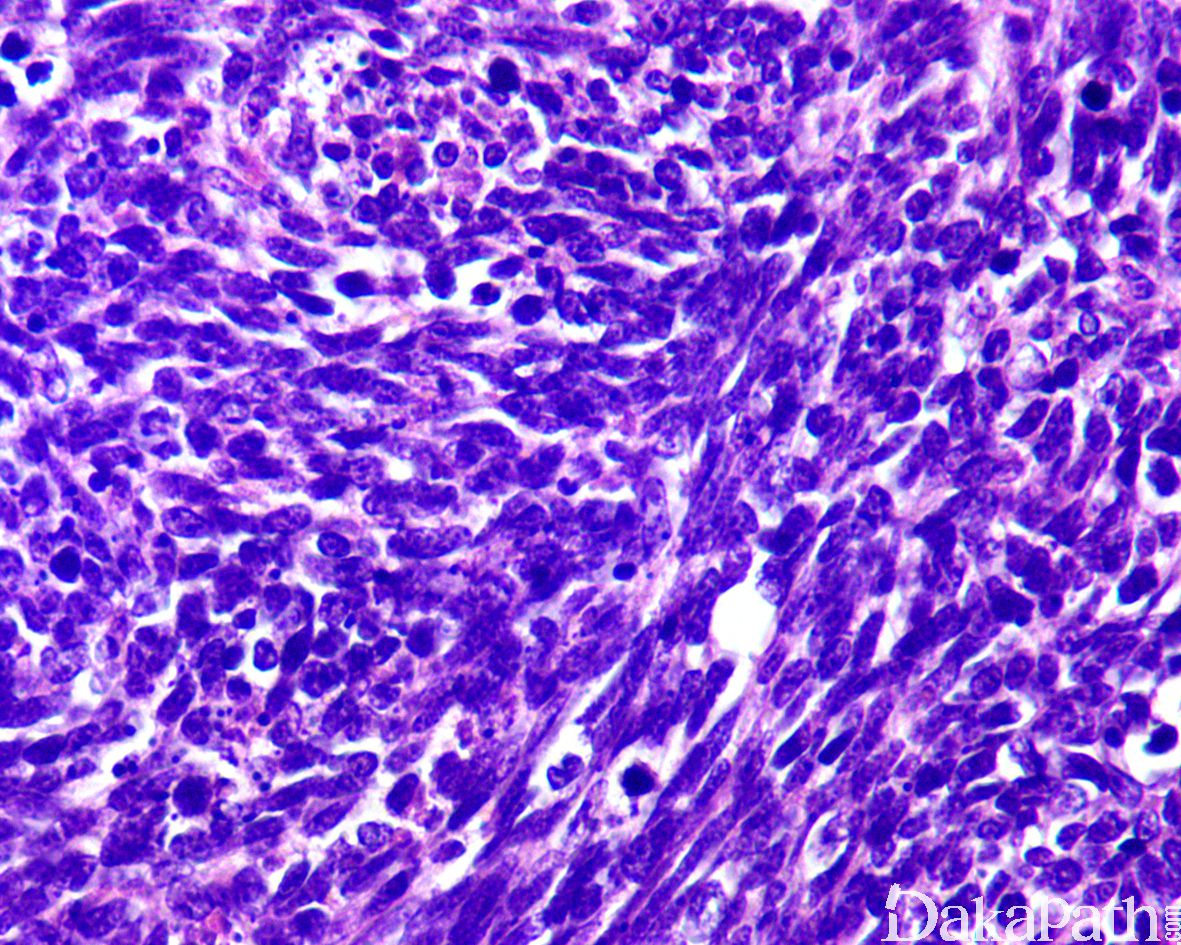

前列腺小细胞神经内分泌癌
Prostate Small Cell Neuroendocrine Carcinoma
同义词(或曾用名): 小细胞癌;高级别神经内分泌癌
概述:
是一种高级别神经内分泌癌,与其他部位发生的小细胞癌具有相似的形态学特征
发病部位: 前列腺
诊断要点:
1.50-60%的前列腺小细胞癌为纯的小细胞神经内分泌癌,其余部分与其他类型的前列腺腺癌混合存在,最常见为高级别前列腺腺泡性腺癌(85%以上为 Gleason 评分 8 分或以上),在混合性病例中,小细胞与腺泡性腺癌成分通常突然过渡,无移行区;
- 许多小细胞癌患者有前列腺腺泡腺癌的激素治疗史;进展间隔 1-300 个月(中位时间 25 个月)
- 形态学与肺的小细胞癌相同,低倍镜下突出的印象是肿瘤区域染色深,由弥漫性生长的小细胞(体积相当于 3 倍于小淋巴细胞)组成,少见器官样结构,呈实性片状、条索状或小梁状排列;
- 在穿刺活检标本中,瘤细胞细胞浆少受挤压使得界限不清;细胞核呈圆形、卵圆形、燕麦样或短梭形,染色质细颗粒状,核仁小或无,核分裂像和凋亡小体多见;约 40%左右的病例中瘤细胞可表现为中间型细胞大小,胞浆稍丰富,染色质开放,可见细小核仁,出现这些细胞并不能排除小细胞癌的诊断;偶尔可见散在分布的瘤巨细胞,具有奇异型核,但仍保留经典的小细胞癌的染色质特征
- 常见广泛的坏死,间质纤细、少,血管较丰富。

免疫组织化学染色:
免疫组化对于前列腺小细胞癌的诊断并非必须,但通常用于对形态学印象的证实。瘤细胞通常 CAM5.2(核旁逗点状)、CgA、Syn、CD56. NSE、TTF-1(> 50%的病例阳性)、P53 等常阳性,AR,NKX3.1,PSA 及 PAP 通常阴性或仅为局灶阳性,约 1/3 可表达 P63 和高分子质量角蛋白(通常为局灶),Ki67 > 50%
分子标记:
约半数左右存在 TMPRSS2-ERG 基因融合,与普通的腺泡性腺癌不同,尽管存在该融合基因,前列腺小细胞癌通常不表达 ERG
鉴别诊断:
高级别前列腺腺泡性腺癌:无小细胞癌的染色质特征,免疫组化染色通常至少表达 PSA、PSAP 或 P501s 的一种,AR 通常阳性,P53 阴性,神经内分泌标志物通常阴性,TTF1 阴性;
转移性小细胞癌累及前列腺:多数为尿路上皮的小细胞癌,少数可为非小细胞癌转移,影像学结合病史通常可助于诊断,查找到伴随的普通型腺泡性腺癌支持为前列腺原发的诊断,TTF1 对于与肺小细胞癌的区分无作用,在困难的情况下可借助 TMPRSS2-ERG 基因融合进行区分,融合基因阳性支持为前列腺原发。
预后:
预后差。在诊断时通常存在远处转移,
治疗:
多药物治疗,包括抗雄激素治疗、放疗和化疗等。
病例报道:
A useful treatment for patients with advanced mixed-typesmall cell neuroendocrine carcinomaof theprostate: Acasereport.
参考文献:
Moch H, Humphrey P A, Ulbright T M, et al. WHO Classification of Tumours of the Urinary System and Male Genital Organ [M]. Lyon: IARC, 2016.
